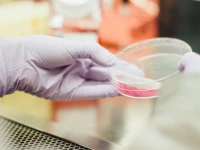

From the Bishops
The epidemic and its cure
I’ve always loved the movies, and one of the scariest films in recent memory is 28 Days Later, released in... Read more
Our response to Charlottesville
In the late 1940s, Archbishop Joseph Rummel began the process of ending segregation in the parishes, seminary, and schools of... Read more
A word about useful tools
History is full of great quotations that people never said. One of the best lines comes from Vladimir Lenin. He... Read more
A Letter to the Romans
Christians are always, in a sense, outsiders. We have the joy and privilege to be a leaven for good in... Read more
A cathedral: more than a beautiful building
When Constantine legalized the Christian faith with the Edict of Milan in 313 A.D., the Church emerged from Rome’s subterranean... Read more
The Importance of Humanae Vitae
A bishop attends a lot of worthy public events and fundraisers. It’s part of the job. And supporting good people... Read more
The Pledge of Allegiance: America’s Need of a Reawakening
In the early 1890s, patriotism in America was very low. The fires of the Civil War had been extinguished and... Read more
Persecution yesterday and today: the moment to be bold
According to a report issued by the Center for Studies on New Religions, there were 90,000 Christians killed for their... Read more
Religious Liberty: Hallmark of a Truly Tolerant Society
In June 2013, the European Union adopted “Guidelines on the Promotion and Protection of Freedom of Religion or Belief.” At... Read more
The ‘polite persecution’ not so polite
In 2007, U.S. Secretary of State Condoleezza Rice established the International Women of Courage Award. It is presented to women... Read more
Scouting in the Balance
I was dismayed to learn this past January that the Boy Scouts of America decided to end their practice of... Read more
The Other Side of Mercy: The Resolve to Sin No More
In 1975, Raymond Moody published the bestseller Life After Life. In it, he coined the term “near-death experience” to label... Read more
Modern Reproductive Technology: Medicine or Eugenics
On Sept. 27, 2016, New Scientist, a weekly international magazine, reported that a team of American scientists had produced the... Read more
Sacred Music
Because we are Catholic, sacred liturgical worship should be at the center of our lives. Jesus Christ is present among... Read more
New Ideologies: A Tower of Babel
Two years ago, Rachel Dolezal enjoyed a good reputation as a civil rights activist and a well-respected professor at Eastern... Read more
Truthful News: A Cornerstone of a Free Society
In 1605, Johann Carolus printed the first weekly newspaper in Antwerp. However, his was not the first effort to keep... Read more
On Our Duty to Welcome the Stranger
For immigrants and refugees now in the United States, or who hope to come here in the near future, recent... Read more
Let’s Be Honest: It’s a Lack of Faith
A “Shoe” cartoon I saw the other day said this: “A recent study has shown that six of the seven... Read more
Praying Ad Orientem
The Kabba of Mecca is Islam’s most holy shrine. It is said to have been built by Abraham and his... Read more